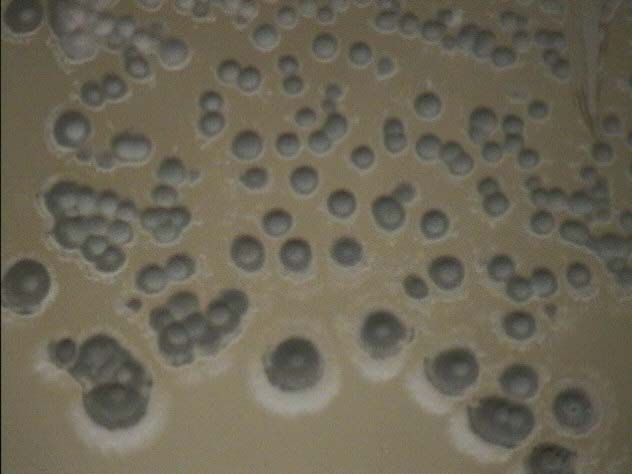
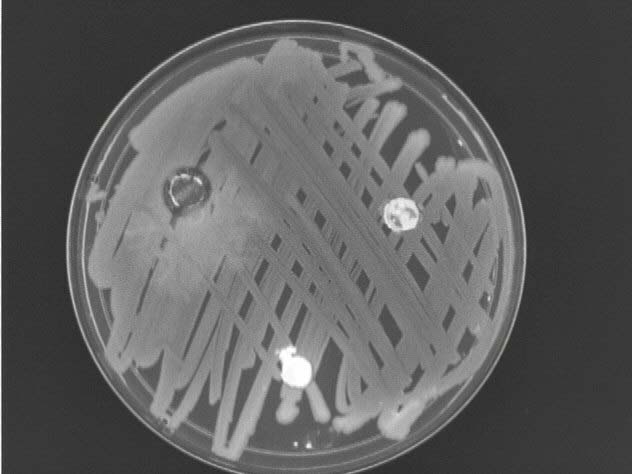

| Streptomyces grown on a Starch-Casein Plate |
 |
Colonies appear round and milky with a brighter white ring around the
outside. Each colony has what seems to be a hard coat covering the
top. As the colonies were allowed to mature, they started to burrow
into the agar. |
| Gram Stain |
 |
Long purple filamentous strands. Gram stain suggests the organism
is gram positive. |
| MacConkey Plates |
No growth |
No growth confirms the fact that organism is gram positive. |
| Catalase |
Postive |
Bubbles formed with the addition of hydrogen peroxide. |
| Oxidase |
Negative |
No blue was seen, suggesting that the organism does not have oxidase
activity and therefore the organism does not contain cytrochome oxidase. |
| Motility Stab |
Non-motile |
Organisms only grew only the stab line suggesting the bacteria is non-motile.. |
| Smell |
Soil Smell |
A distinct odor is noticed whenever the top of the agar plate
is removed. This odor is one of the defining features that identify
Streptomyces.
Streptomyces
produces this odor and this is where dirt gets its smell from. |
| Antibiotic Test |
 |
1. Top Far Right - No zone of inhibition was seen implying that this
organism does not inhibit the growth of gram-negative organisms.
2.Top Far Left - Zone of inhibition show that this particular
organism inhibits the grow of gram-negative organisms.
3. Bottom Center - No zone of inhibition was seen implying that this
organism does not inhibit the growth of gram-negative organisms. |